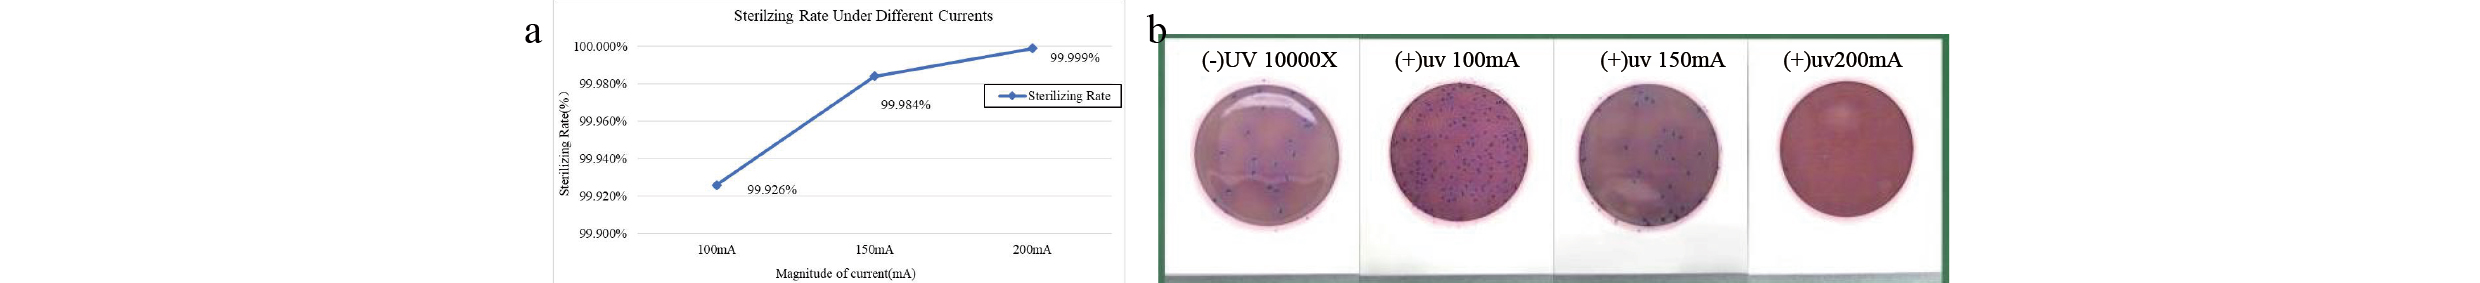
اختبارات تطهير المياه في التيارات المختلفة.

الكاتب:محرر الموقع نشر الوقت: 01-08-2025 المنشأ:محرر الموقع
Eason Liao 1،* ، Xiaoxiao Wang 1، Qing Zhang 1، Shuzhong Li 1, Jiancheng Wang1
1Massphoton Limited Hong Kong ، Hong Kong ، HK1100
خلاصة.
تبحث هذه الدراسة بشكل منهجي في تحسين أداء وحدات تطهير المياه UV-C LED ، مع التركيز على آثار مواد تبديد الحرارة ، وتصميم التيار ، وتصميم البنية البصرية على كفاءة التعقيم. توضح النتائج أن ركائز النحاس تقلل بشكل كبير من معدل توهين طاقة الضوء لمصابيح LED UV-C مقارنة بركائز الألومنيوم (41.90 ٪ مقابل 53.94 ٪) ، وبالتالي تمديد عمر التشغيل للجهاز. في تجارب تطهير المياه ، فإن زيادة التيار الدافعة (من 100 مللي أمبير إلى 200 مللي أمبير) يعزز بشكل ملحوظ كفاءة تعطيل ، مما يحقق معدل تعطيل القولون الإشريكية القولونية البالغ> 99.999 ٪ في 200 مللي أمبير ، والذي يلبي معايير تطهير مياه الشرب. علاوة على ذلك ، من خلال تحسين التصميم البصري ، تم تخفيض عدد حبات LED UV-C من ستة إلى أربعة ، وتم استخدام ثقوب فردية لكل حبة لتعزيز انعكاس الأشعة فوق البنفسجية. حافظ هذا النهج على معدل تعقيم مرتفع قدره 99.999 ٪ مع تقليل التكاليف بنسبة 33 ٪. توفر هذه الدراسة أسسًا نظرية حرجة ومراجع هندسية لتصميم أنظمة تطهير المياه UV-C الفعالة والفعالة من حيث التكلفة وطويلة الأمد.
الكلمات المفتاحية: تطهير الماء ، UV-C LED ، Escherichia coli ، معدل التعقيم ، خالي من الزئبق ، UV-C LED ، تطهير الماء.
1 مقدمة
تعتبر سلامة المياه مصدر قلق عالمي حاسم ، حيث أن استهلاك المياه الملوثة بالبكتيريا المسببة للأمراض ، والبروتوزوا ، والفيروسات يمكن أن تؤدي إلى أمراض تنقلها المياه في البشر والحيوانات ، بما في ذلك التهاب المعدة والأمعاء ، التهاب عضلة القلب ، التهاب الدماغ ، حمى البشر [-3]. تعد استراتيجيات التطهير الفعالة لتنشيط الفيروسات التي تنقلها المياه ضرورية في عمليات معالجة المياه ، لأنها تضمن القضاء على الكائنات الحية الدقيقة المسببة للأمراض المسؤولة عن الأمراض التي تنقلها المياه. تشمل أساليب وتقنيات التطهير الشائعة للتعطيل الفيروسي في الماء العلاجات الكيميائية التقليدية مثل الكلور ، وكذلك طرق التطهير المادية مثل ترشيح الغشاء وإشعاع الأشعة فوق البنفسجية (UV) [4].
في مجال تطهير مياه الشرب ، يتم استخدام طرق التطهير الكيميائي التقليدية ، مثل الكلور ، أحادي كلورامين ، وثاني أكسيد الكلور ، على نطاق واسع [5]. يستحث الكلور طفرات في الحمض النووي الميكروبي عن طريق تغيير تسلسل البيورين والبيريميدين ، وتعطيل تخليق البروتين ونقل الجلوكوز ، وبالتالي تثبيط التكاثر الميكروبي [6]. ومع ذلك ، هناك عيب كبير في أن الكلور يتفاعل مع المواد العضوية في الماء لتشكيل منتجات ثانوية للتطهير ، مثل ثلاثي الأثريثان ، التي تشكل مخاطر مسببة للسرطان وخيبة الأوساخ على صحة الإنسان [7]. ترشيح الغشاء هو تقنية فعالة تزيل الجزيئات المعلقة والبكتيريا والمواد العضوية من مياه الشرب ومياه الصرف الصحي عن طريق تمرير المياه عبر حاجز مادي. ومع ذلك ، فإن فعالية التطهير تتأثر بجودة المياه ، ومحتوى الجزيئات الصلبة ، والتلوث أثناء عملية المعالجة. علاوة على ذلك ، تنخفض نفاذية الغشاء مع زيادة الوقود الحيوي ، مما يقلل من قدرتها على الاحتفاظ بالفيروسات [8].
لقد استحوذ تشعيع الأشعة فوق البنفسجية ، كطريقة تطهير جسدي ، على اهتمام كبير في تعطيل الميكروبات بسبب مزاياه الملحوظة ، بما في ذلك عدم وجود إضافات كيميائية ونقص المنتجات الثانوية للتطهير [9]. ومع ذلك ، فإن تكنولوجيا التطهير التقليدية للأشعة فوق البنفسجية القائمة على الزئبق لها عدة قيود ، بما في ذلك: 1) خطر تلوث الزئبق ؛ 2) عمر المصباح القصير (عادة من 5000 إلى 9000 ساعة) ؛ 3) أوقات الاحماء الطويلة (3-5 دقائق) ؛ 4) كفاءة تحويل الطاقة المنخفضة (حوالي 30-40 ٪) ؛ و 5) الحجم الضخم مع قدرة التبديل عالية التردد. في المقابل ، توفر تقنية UV-C التي تنبعث منها الضوء (LED) المستندة إلى مواد GAN مزايا مهمة: 1) خالية من الزئبق وصديقة للبيئة ؛ 2) عمر طويل للغاية (يتجاوز 20،000 ساعة) ؛ 3) وظيفة التشغيل/الإيقاف الفوري (وقت الاستجابة <1 μs) ؛ 4) الطول الموجي قابل للضبط (260-280 نانومتر) ؛ 5) حجم مضغوط (حجم رقاقة <1 مم مربع) ؛ و 6) دعم العملية النبضية عالية التردد [10-13]. تضع هذه الخصائص LED UV-C كخيار مثالي لتقنيات التطهير المائية من الجيل التالي.
في السنوات الأخيرة ، تم إحراز تقدم كبير في تطبيق تقنية LED UV-C للتنشيط الميكروبي. بناءً على الأبحاث السابقة ، تعمل هذه الدراسة بشكل منهجي على تحسين معلمات أداء وحدات تطهير المياه UV-C LED ، مع التركيز على التحقيق في الآليات التي تؤثر من خلالها لخصائص مواد تبديد الحرارة ، ودفع شدة التيار الحالي ، وتصميم البنية البصرية كفاءة التعقيم. توفر هذه النتائج الدعم الفني الحاسم لتطوير أنظمة معالجة المياه UV-C عالية الكفاءة عالية الكفاءة ، مع تطبيقات واسعة في تنقية مياه الشرب ، وتطهير المياه المنزلية ، ومعالجة إمدادات المياه الصناعية ، مما يوفر فوائد اجتماعية وقيمة عملية.
2 مادة وطريقة
2.1 Massphoton UV-C LED حبة
توظف هذه الدراسة رقائق UV-C ذات الطاقة العالية 270-280 نانومتر (GAN) ، مما يحقق رابطة عالية الجودة بين الرقاقة والركيزة الخزفية من خلال عملية لحام تناقص محسنة. توضح النتائج التجريبية أن تقنية التغليف هذه تقلل بشكل كبير من نسبة فراغ الواجهة ، مما يقلل من المقاومة الحرارية إلى 8.2 ك/ث ، والذي يمثل تحسنًا بنسبة 40 ٪ تقريبًا في كفاءة تبديد الحرارة مقارنة بطرق الترابط اللصق الفضية التقليدية. يستخدم بنية التغليف زجاج JGS1 كوارتز عالي النقل كأنه نافذة إخراج الضوء ، مع اختبارات مقياس الطيف تشير إلى إرسال أكثر من 90 ٪ عند طول الموجة 270 نانومتر. تكشف اختبارات الشيخوخة المتسارعة (85 درجة مئوية/85 ٪ RH) أن الجهاز المغلف يحافظ على حوالي 90 ٪ من قوته البصرية الأولية بعد 1000 ساعة من التشغيل المستمر ، مما يعزز بشكل كبير موثوقية وعمر أجهزة LED UV-C. يوفر نهج التغليف المحسن هذا الدعم الفني القوي لتطبيق مصابيح LED العميقة في حقول التعقيم والتطهير.

الشكل .1. LED Massphoton UV-C المعبأة
2.2 عينات الميكروبات
كانت سلالة الاختبار المستخدمة الإشريكية القولونية (8099). تم شراء الجيل الثاني من E. coli (8099) ، وتراجع على لوحات أجار للتنشيط ، ثم يستخدم لإعداد تعليق بكتيري. تم تلقيح الثقافات المائلة E. coli الطازجة من الأجيال الثالثة إلى السابعة ، المحتضنة عند 36 ± 1 درجة مئوية لمدة 18-24 ساعة ، في وسط سائل LB ومثبتة في حاضنة درجة حرارة ثابتة عند 36 ± 0.5 درجة مئوية لمدة 16-20 ساعة. بعد انتشار بكتيري كبير ، تم تخزين الثقافات في درجة حرارة الغرفة للاستخدام اللاحق.
2.3 طريقة الكشف
يتبع الإجراء التجريبي التذييل E من GB28235-2020 ، المتطلبات الصحية لجهاز الأشعة فوق البنفسجية للتطهير ، وتحديدا طريقة اختبار تعطيل الميكروبات المخبرية لتطهير الماء. بالنسبة للمطهرات المستخدمة في معالجة مياه الشرب ، كانت عينة مياه الاختبار ملوثة بعلقة القولون الإشريكية القولونية المضافة إلى ماء الصنبور المكلور أو الماء المقطر ، وتحقيق تركيز بكتيري قدره 5 × 10⁴ CFU/100 مل إلى 5 × 10⁵ CFU/100 مل. تم تقسيم عينات المياه إلى مجموعة مراقبة فارغة (غير معالجة) ومجموعة تجريبية (عينات المياه التي تم جمعها بعد المرور عبر وحدة تطهير المياه UV-C LED بمعدل تدفق محدد ، على سبيل المثال ، 4 لتر/دقيقة أو 9 لتر/دقيقة). تم تحديد عدد المستعمرة البكتيرية الكلية في كلا المجموعتين باستخدام طريقة حساب اللوحة القياسية ، وتم حساب تعطيل لوغاريتمي (تعثر السجل).
3 النتيجة والمناقشات
3.1 الارتباط بين شدة التشعيع ومواد وحدة الماء
تستخدم وحدة تطهير مياه Massphoton (الشكل 2) تقنية تطهير UV-C خالية من الزئبق ، مما يلغي بشكل أساسي خطر تلوث المعادن الثقيلة المرتبطة بمصابيح الزئبق التقليدية. يتم تغليف الوحدة في الفولاذ المقاوم للصدأ من الدرجة الطبية 316L ، مما يمنع إطلاق أيونات المعادن الضارة أثناء ملامسة المياه المطولة. تتميز الوحدة بتصميم بصري مغلق بالكامل ، مع إغلاق جميع مصادر الإضاءة فوق البنفسجية داخل الغلاف ، مما يضمن عدم وجود خطر التعرض للإشعاع أثناء التشغيل. يتم إغلاق المدخل والمخرج بمقاطع سيليكون من فئة الطعام ، والتي اجتازت اختبارات ضغط الماء تتراوح من 0.35 إلى 0.7 ميجا باسكال واختبارات تشغيلية طويلة الأجل بمعدل تدفق 4 لتر/دقيقة دون أي تسرب ، مما يدل على أداء ختم ميكانيكي ممتاز. يضمن هذا التصميم كفاءة تعقيم عالية مع تلبية متطلبات السلامة والموثوقية الكاملة لمعدات معالجة مياه الشرب.
التين .2. الرسم البياني الفيزيائي لوحدة تطهير ماء Massphoton
نطاق كفاءة التشغيل الأمثل لخرز LED UV-C هو 25 درجة مئوية-60 درجة مئوية. قد يؤدي تجاوز نطاق درجة الحرارة هذا إلى توهين الطاقة الخفيفة أو تحول الطول الموجي ، مما يجعل الإدارة الحرارية الفعالة أمرًا بالغ الأهمية لضمان أداء تعقيم وحدات تطهير المياه. المواد المعدنية ، بسبب الموصلية الحرارية الممتازة ، يمكن أن تقلل بشكل فعال من درجة حرارة تشغيل حبات LED. لمقارنة أداء التبديد الحراري للركائز المعدنية المختلفة ، اختارت هذه الدراسة ركائز النحاس والألومنيوم كمواد أساسية لخرز UV-C LED واختبرت اختلافات درجات الحرارة على مدار 30 دقيقة من التشغيل المستمر في كل من ثابت (لا تدفق المياه) وظروف ديناميكية (تدفق المياه).
تشير النتائج التجريبية إلى أنه في ظل كل من الظروف الثابتة والديناميكية ، كانت درجات الحرارة التشغيلية لـ UV-C مع ركائز النحاس والألومنيوم متشابهة ، ولا تُظهر فروق ذات دلالة إحصائية (الشكل 3A). ومع ذلك ، في اختبار الشيخوخة لمدة 30 دقيقة ، أظهرت UV-C LED مع الركيزة النحاسية تشعيعًا أوليًا 420 μW/CM⊃2; ، والتي انخفضت إلى 244 μW/CM⊃2; ، مما أدى إلى معدل توهين طاقة خفيفة (PD) البالغ 41.90 ٪. في المقابل ، كان لـ UV-C LED مع الركيزة من الألومنيوم تشعيعًا أوليًا يبلغ 350 μW/cm² ، والذي انخفض إلى 161 μW/cm² ، مع معدل توهين PD قدره 53.94 ٪ (الشكل 3 ب).
تشير هذه النتائج إلى أنه على الرغم من أن أداء التبديد الحراري على المدى القصير للركائز المعدنية قابلة للمقارنة ، فإن ركائز النحاس أكثر فاعلية تخفيف توهين الطاقة الخفيفة على المدى الطويل لـ UV-C ، مما يمتد عمرًا تشغيليًا لوحدات التطهير المائية. توفر هذه النتائج إرشادات كبيرة للتصميم الحراري لأنظمة معالجة المياه UV-C LED ، والتوصية بالاستخدام التفضيلي للركائز النحاسية كمواد تبديد الحرارة في تطبيقات عالية الطاقة.


تين . 3. اختبارات درجة الحرارة والشيخوخة لركائز شريط LED UV-C مع مادتين مختلفتين. أ. اختلافات درجة الحرارة للمادة تحت ساكنة (بدون ماء) وظروف المياه المتدفقة ؛ ب. مقارنة توهين الإشعاع فوق البنفسجي للمادة كركائز.
3.2 دراسة حول فعالية التعقيم لـ UV-C LED تحت التيارات المختلفة
لسيناريوهات تطهير المياه ، تم التحقيق في فعالية تعطيل LED UV-C ضد Escherichia Coli (ATCC 8099) تحت التيارات القيادة المختلفة. استنادًا إلى الدراسات السابقة ، يتطلب تحقيق تعطيل 5-log (99.999 ٪) في وقت اتصال لمدة ثانية واحدة جرعة إشعاعية الأشعة فوق البنفسجية من 40 إلى 60 ميجا جول/سم. استخدمت التجربة مجموعة من ستة حبات LED UV-C التي تنتجها MassPhoton ، التي تم اختبارها في التيارات التي تصل إلى 100 مللي أمبير ، 150 مللي أمبير ، و 200 مللي أمبير. توضح النتائج (الشكل 4A) وجود علاقة إيجابية كبيرة بين كفاءة تعطيل البكتيريا وقيادة التيار: عند 100 مللي أمبير ، تم تحقيق كفاءة تعطيل قدرها 99.926 ٪ ؛ عند 150 مللي أمبير ، زادت الكفاءة إلى 99.984 ٪ ؛ وفي 200 مللي أمبير ، حقق النظام باستمرار كفاءة تعطيل تتجاوز 5 نسبة (99.999 ٪) ، وتلبية المتطلبات الصارمة لتطهير مياه الشرب.
تؤكد هذه النتائج أن تحسين تيار القيادة يمكن أن يعزز بشكل فعال أداء تعقيم أنظمة LED UV-C. في تيار يعمل من 200 مللي أمبير ، استوفى النظام متطلبات التطهير المعيارية للصناعة (NSF/ANSI 55) ، مما يوفر أدلة تجريبية مهمة لتصميم المعلمات الهندسية لأنظمة التطهير المائية UV-C LED.

الشكل . 4 . (أ) معدلات تطهير المياه في التيارات المختلفة ؛ (ب) نتائج تطهير المياه في التيارات المختلفة
3.3 دراسة حول تأثير كمية حبة UV-C LED ومواد التحويل العالية على كفاءة التعقيم
حققت هذه الدراسة هدف تعزيز كفاءة التعقيم مع تقليل التكاليف من خلال تحسين ترتيب حبة UV-C LED وتصميم الهيكل البصري. تشمل التحسينات المحددة ما يلي: 1) تقليل عدد حبات UV-C LED من ستة إلى أربعة ، مما يقلل بشكل كبير من تكاليف الإنتاج ؛ 2) تعديل مزيج من مواد الانتقال العالية عن طريق الانتقال من تصميم واحد افتتاح واحد تقليدي لشريط الضوء بأكمله إلى تصميم افتتاح مستقل لخرز LED الفردي. توضح بيانات اختبار أداء التعقيم (الجدول 1) أن الهيكل الأمثل ، على الرغم من انخفاض 33 ٪ في كمية حبة LED ، يحافظ على ارتفاع معدل تعطيل قدره 99.999 ٪ ضد الإشريكية القولونية في المياه المتدفقة عند 4 لتر/دقيقة. توفر هذه النتائج مرجعًا قيمة للتصميم الفعال من حيث التكلفة وعالي الكفاءة لمعدات التعقيم UV-C.
الجدول 1. نتائج اختبار التعقيم لأعداد مختلفة من حبات UV-C LED

4 استنتاجات
قامت هذه الدراسة بتقييم بشكل منهجي معلمات الأداء الرئيسية لوحدات التطهير المائية UV-C LED ، بما في ذلك اختيار مواد تبديد الحرارة ، وتحسين قيادة تيار ، وتصميم ترتيب حبة LED والبنية البصرية ، مما يوفر رؤى حرجة لتطوير أنظمة تعقيم UV-C الفعالة وفعالة من حيث التكلفة. تشير النتائج التجريبية إلى أن ركائز النحاس والألومنيوم تظهر أداء تبديد الحرارة على المدى القصير. ومع ذلك ، تُظهر ركائز النحاس الاستقرار المتفوق على المدى الطويل ، مع انخفاض معدل توهين طاقة الضوء بشكل ملحوظ (41.90 ٪) مقارنة بركائز الألومنيوم (53.94 ٪). يشير هذا إلى أن ركائز النحاس أكثر فعالية في الحفاظ على إخراج UV-C مستقر في أنظمة التطهير المائية عالية الأجل ، وبالتالي تمديد عمر التشغيل للمعدات. كشف التحقيق في تأثير قيادة التيار على كفاءة التعقيم أن زيادة التيار يعزز بشكل كبير أداء التطهير لمصابيح LED UV-C. في تيار القيادة الذي يبلغ 200 مللي أمبير ، حقق النظام باستمرار معدل تعطيل الإشريكية القولونية بنسبة 99.999 ٪ ، ويتوافق تمامًا مع معايير تطهير مياه الشرب (NSF/ANSI 55). من خلال تقليل عدد حبات UV-C LED من ستة إلى أربعة وتحسين التصميم البصري (دمج الثقوب الفردية لكل حبة وتعزيز الهياكل العاكسة) ، تم الحفاظ على معدل تعقيم مرتفع 99.999 ٪ مع تقليل تكاليف الأجهزة بنسبة 33 ٪. لم يحسن هذا التحسين كفاءة استخدام الطاقة الضوئية فحسب ، بل أدى أيضًا إلى خفض تكاليف الإنتاج ، مما يوفر حلاً قابلاً للتطبيق للاعتماد التجاري لأنظمة التطهير UV-C LED.
باختصار ، حققت هذه الدراسة تحسينات شاملة في الأداء وفعالية التكلفة وموثوقية وحدات تطهير المياه UV-C LED من خلال تحسين المواد ، وتعديلات المعلمات الكهربائية ، والابتكارات الهيكلية. يمكن أن تستكشف الأبحاث المستقبلية الاستقرار على المدى الطويل لمصابيح LED UV-C ذات الطاقة العالية وتأثير ظروف جودة المياه المختلفة (على سبيل المثال ، التعكر والمحتوى العضوي) على كفاءة التعقيم لتعزيز تطبيق هذه التكنولوجيا في مجموعة أوسع من السيناريوهات.
مراجع
1. غريفيث ، جيه كيه ، الأمراض التي تنقلها المياه. الموسوعة الدولية للصحة العامة (الطبعة الثانية) ، 2017: ص. الصفحات 388-401.
2. Lanrewaju AA ، EASS ، مراجعة على طرق التطهير لتعطيل الفيروسات التي تنقلها المياه. Front Microbiol ، 2022 (13: 991856. Doi: 10.3389/FMICB.2022.991856. PMID: 36212890 ؛ PMCID: PMC9539188.).
3. Lanrewaju AA ، Eass ، تداعيات الصحة العامة العالمية على التعرض البشري للمياه الملوثة الفيروسية. الميكروبول الأمامي ، 2022 (13: 981896. doi: 10.3389/fmicb.2022.981896. PMID: 36110296 ؛ PMCID: PMC9468673.).
4. Crolivignarelli MC ، AABI ، نظرة عامة على عمليات التطهير الرئيسية لمحطات معالجة مياه الصرف الصحي ومياه الشرب. الاستدامة ، 2018 (10:86.).
5. شياو ، ر. مجلة إمدادات المياه: الأبحاث والتكنولوجيا ، 2020. 69 (7/8): ص. 785-806.
6. كومار س. ، GAKM ، المعالجة الكيميائية لإزالة مسببات الأمراض المنقولة بالمياه. مسببات الأمراض التي تنقلها المياه ، 2020 (205-218. DOI: 10.1016/B978-0-12-818783-8.00011-6).
7. Gall AM ، SJLM ، حركية تعطيل وتثبيط دورة التكرار في فيروس الغد بواسطة أحادي كلورامين. البيئة. SCI. تقنية. Lett. ، 2016.3 ، 185-189.
8. Chen C. ، Glyy ، الفعالية المقارنة لتقنيات الغشاء وطرق التطهير للقضاء على الفيروسات في الماء: مراجعة. SCI. Total Environ. ، 2021 (801: 149678. doi: 10.1016/j.scitotenv.2021.149678).
9. Oguma K. ، RS ، تعطيل الأشعة فوق البنفسجية للفيروسات في الماء: إمكانية تخفيف التهديدات الحالية والمستقبلية للأمراض المعدية الفيروسية. JPN. J. Appl. Phys. ، 2021 (60: 110502).
10. Nyangaresi PO ، QYCG ، مقارنة بين أداء التشعيع النبضي والمستمر الذي تقوده الأشعة فوق البنفسجية في تعطيل البكتيريا. Water Res. ، 2019.157: 218-227.
11. Pelayo D ، HASG ، أداء LED UV-C عالي الكفاءة في تطهير المياه: التقييم التجريبي ، تقييم دورة الحياة ، والتحليل الاقتصادي للسيناريوهات التشغيلية المختلفة. J Environ Manage. ، 2024.364: 121442.
12. Würtele MA ، KTLM ، تطبيق ثنائيات ضوء الأشعة فوق البنفسجية القائمة على GAN-LEDS-لمطهر الماء. Water Res. ، 2011 (45 (3): 1481-9.
13. Mohaghegh Montazeri M ، HSTF ، التصوير المائي للضوء فوق البنفسجي (UV-LED): مراجعة. J Environ Manage ، 2025 (386: 125678. Doi: 10.1016/J.Jenvman.2025.125678. Epub 2025 May 14. Pmid: 40373433.
ابق على اطلاع بأحدث المستجدات لدينا من أخبار، تقنيات، وفعاليات.